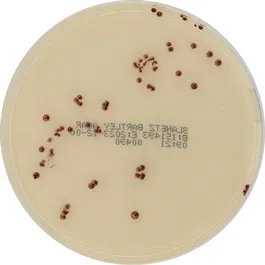

Slanetz Bartley Agar
01-579
ISO
Differential selective medium for the detection and enumeration of enterococci according to ISO 7899-2 standard. This medium need to add 1% TTC sterile solution (Art. No.:06-023).
The prepared medium (Art.No.:064PF6017P) not containing the additive TTC 1%.
Synonyms: m-Azide Agar, m-Enterococcus Agar, m-Slanetz Enterococcus Agar
ISO
Differential selective medium for the detection and enumeration of enterococci according to ISO 7899-2 standard. This medium need to add 1% TTC sterile solution (Art. No.:06-023).
The prepared medium (Art.No.:064PF6017P) not containing the additive TTC 1%.
Synonyms: m-Azide Agar, m-Enterococcus Agar, m-Slanetz Enterococcus Agar

01-579
ISO
Differential selective medium for the detection and enumeration of enterococci according to ISO 7899-2 standard. This medium need to add 1% TTC sterile solution (Art. No.:06-023).
The prepared medium (Art.No.:064PF6017P) not containing the additive TTC 1%.
Synonyms: m-Azide Agar, m-Enterococcus Agar, m-Slanetz Enterococcus Agar
Features
+See More
+See More

 Rest of the World
Rest of the World






